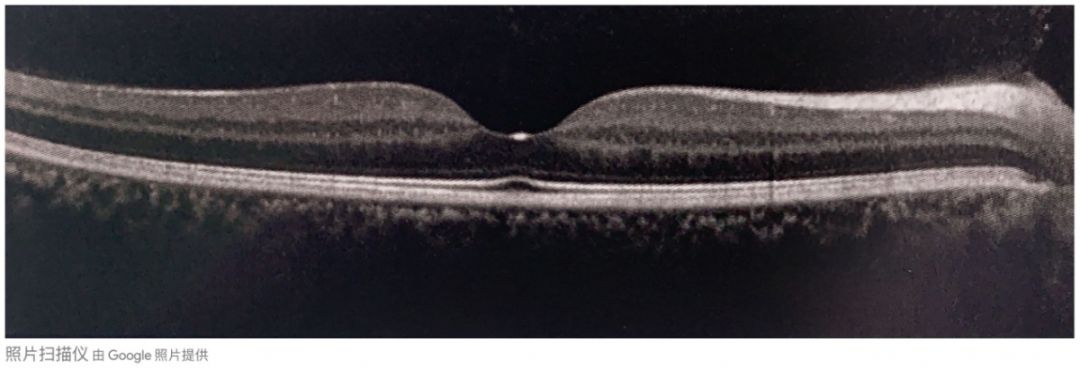
眼底黄斑病变一般多久会失明,眼底黄斑病的养护和注意事项

眼底“黄斑”是怎么回事?该如何自检?及在生活中该如何注意防护?
门诊病人有带着疑问来的:“大夫,我眼底长黄斑了,怎么办啊?”
也有带着焦虑来的:“我黄斑病变,将来会什么都看不见了吗?”
“大夫,我黄斑有病变,白内障做了也没有用吧?”
“我眼底黄斑病变好几年了,现在白内障又明显了,还值得做吗?”
我们先看看眼底黄斑是怎么回事吧。

眼底视网膜照片
这是一张大致正常的眼底视网膜照片,可以看见视盘和血管分布,箭头所示为视网膜的黄斑区,每只眼睛视网膜都有一个黄斑,不是眼底“长斑”了,而是这个部位的名称就叫“黄斑 ”。
黄斑直径约2.85mm,其中央有一个直径1.5mm的凹陷,称为“黄斑中心凹”,是视觉最敏锐的部位。黄斑掌管着我们的中心视力、色觉和形觉,让我们拥有精细视觉和彩色的世界。

鲜艳的色彩
黄斑以外视网膜的视力是极其低下的,掌管着黑白视觉,对应的是我们的视野,即“眼睛的余光”。
大致来说,到医院检查视力看视力表的时候,查颜*图色**谱的时候,查的都是黄斑的功能;而检查视野的时候,查的是黄斑以外视网膜的功能。
所以单纯局限的黄斑区病变一般是不会导致全盲的,但是患者越想看哪儿,哪儿就越不清楚,中心视力很差,中心以外的视野还是可见的。
当你发现自己看东西出现中央黑点遮挡、看东西变形、直立的东西变斜、双眼看颜色不同等情况时,要及时就医。
常用的黄斑检查方法:
大夫直接手持给患者检查眼底用的有:直接和间接眼底镜、视网膜前置镜。
还有以下几种设备检查:

眼底照相
光学相干断层扫描OCT

眼底荧光血管造影FA

眼底自发荧光FAF

光学相干断层血流成像OCTA
黄斑功能对我们的视力至关重要,
保护黄斑注意以下几点:
1、光线太强时需要戴墨镜,尤其是去海边、去雪山等光线刺眼的地方,要做好防护,防止“雪盲”。
2、 不宜长时间看手机、看电脑等,将屏幕光线调节至眼睛感觉舒适的亮度。
3、 避免让儿童玩弄激光笔,激光直射眼睛会造成黄斑灼伤甚至破孔。
4、控制好血糖、血压。
5、戒烟
6、适量食用胡萝卜、玉米、绿叶蔬菜,因其富含叶黄素或玉米黄素,抗氧化能力强,对黄斑有保护作用。
最后给大家介绍一个简单的自我检测黄斑的方法:

图片边长10cm
将表格放置于眼前约30cm处,用一只眼注视中心白点,若出现线条扭曲变形、凹凸等,请就医进一步确诊。
下一期我们来解答这个问题:“我眼底黄斑有病变,现在白内障又明显了,还值得做吗?”
传播眼病防治知识,是我一直在做的事,我将在每周3发布新文章,如果您觉得有用,可以分享给更多的朋友。分享健康,你也能做他人的英雄。
文中图片来源于网络
如有侵权,请联系删除